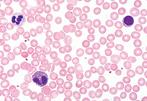

Education



Biomedical Research

Global Leader in Microscopy Solutions
Complete line of microscopes, and digital imaging solutions
Partnering with



EDUCATION AND ROUTINE EDUCATION AND ROUTINE EDUCATION AND ROUTINE
APPLICATIONS APPLICATIONS APPLICATIONS




















BA210S LED Series
Easy to use, easy to operate, educational
Hard-coated stage allows a safe and durable evaluation of diverse sample
Feature a 30° viewing angle for maximum comfort
Adjustable interpupillary distance of 55-75mm
Complete series of EC Plan Achromatic objectives for reliable image results
Optional objectives (positive & negative Phase) show a remarkable diversity for a wide range of applications
Well-evaluated 3W LED illumination system in a Fixed Koehler setup
High-quality condenser with NA 1.25 and aperture diaphragm is implemented


BA410E Series
Routine-lab microscope for transparent samples
The optics starts with the standard EC-H Plan Achromat series from 2X to 100X magnification
Respective Phase contrast objectives (positive & negative version) are derived from these Brightfield lenses
Rackless stage with ceramic insert gives a long-time stability to sample positioning, enabling a fast scanning
Feature a 30° viewing angle for maximum comfort
Adjustable interpupillary distance of 48-75mm
Light memory function based on an encoded 6-fold nosepiece
High-quality condenser with NA 1.25 and aperture diaphragm is implemented
Panthera E2 Series
Newest generation of educational light microscopes
Reversed 4-fold nosepiece, a rackless X/Y-stage with s slide holder and upper limit stop fulfill users demands Equipped with new Ultra Contrast (UC) Plan Achromatic ob in a range from 4X to 100X magnification
The optional 100X/0.8 “Dry objective” is especially favou environments where the time-consuming immersion proc considered as too difficult and complicated
The low consumption LED light source in a Fixed Koehl stands for a “cool” illumination with a long lifetime
A USB port in the stand grants the functionality of the mic independent from the mains by a power bank
Binocular
Fisher Scientific Cat. No. 01-258-020
Trinocular
Fisher Scientific Cat. No. 01-258-041

Panthera Cloud
Smart microscope - upgraded

Panthera C2 Series
Revolutionary technical future-orientated solutions
Bright Field is the standard, Phase Contrast, Pol Contrast, objectives with/without cover glass correction, optional LED Fluorescence modules with variable filter combinations
The new Plan UC Achromatic objectives, from 2X to 100X magnification range, show significantly improved image contrast
A Field of View of 22mm indicates one more step closer to the High-End level of overview
A 30W Halogen bulb can be replaced by a 3W LED of different color temperatures
A Full-Koehler setup for transmitted light is self-evident
Binocular
Fisher Scientific Cat. No. 01-258-022
Simple Phase Package
Fisher Scientific Cat No 01-258-043
Fisher Scientific Cat No 01-258-045
The Smart CAM digital head and its ImagingOnDevice System allows you to instantly capture what you are viewing with the tip of your finger
Work in FullHD through the HDMI port directly on a screen with the help of a mouse, or work with your Tablet and the Panthera App
Send your live image to your tablet or smartphone by simply scanning the QR-code on the top of the Tubehead cover via QRlink system
Connect it to a network to run a DigiClass, for remote sharing or for working with your computer
Trinocular
Fisher Scientific Cat. No. 01-258-042
Phase Package
Fisher Scientific Cat No 01-258-044

AE2000 LED Inverted Series
(with PL PH 20X)
Inverted microscopes for routine microbiology
Flexible optical concept to meet best image quality
Robust design for a long lifetime under rough lab conditions
In full accordance with Motic's CCIS® Infinity System, the LW Plan Achromatic objectives with an ingenious Phase contrast concept deliver a remarkable image quality
20X Phase Contrast objectives are an integral part of package
The AE2000 stand carries a quadruple nosepiece with a pre click stop of objective positions
Rich illumination power is given by the 3 Watt LED light sourc a Fixed-Koehler setup
The Auto ON/OFF function, based on a built-in IR-sen deactivates the microscope in case it is left by the user


ll accordance with Motic’s CCIS© Infinity System, the new LWD Achromatic objectives with an intelligent Phase contrast concept er a remarkable image quality
AE31E stand carries an encoded 5-fold nosepiece
illumination power is given by the 3 Watt LED light source in a Fullhler configuration
pgrade with fluorescence is offered for the entry level of research cations
umentation is facilitated by the 100:0/0:100 light split option for test possible exposure times Upgraded Inverted microscopes for routine microbiology
SMZ-160 Stereo Series
Basic zoom stereo microscopes
Comes with 1:6.4 zoom range (0.75x-4.5x), all metal body illumination
Ball bearing focusing system provides accurate and steple even at high magnifications
The metal body ensures years of use without comprising qual LED illuminated stand state of the art 3W LED illumination temperature close to natural light (5000K-6000K)
Wide range of illumination options can be combined with th optics, such as ring light solution which is recommended for free image
SMZ-160-BLED
Fisher Scientific Cat. No. 01-258-013
SMZ-160-TLED
Fisher Scientific Cat. No. 01-258-015


SMZ-171
Stereo Series
Flexible stereo microscopes
optical performance with improved transmission rates higher magnifications is combined with reliable chanics for daily usage
Greenough optical system delivers crisp and clear ges with a zoom range of 1:6 7 (0 75x-5x)
lick-stops within the smooth zoom allow a precise oduction of magnifications for measuring purposes
rge Field of View is ensured by the standard 10X/23 pieces
large working distance of 110mm gives sufficient ce for preparation and repair work, using the stunning th of view for a convincing 3D upright image
MZ-171-BLED
Fisher Scientific Cat. No. 01-258-017
SMZ-171-TLED
Scientific Cat. No. 01-258-019
Moticam 4000X
Fisher Scientific Cat. No. 01-001-647
HD affordable multi-tasking camera with 4K (3840*2160) Resolution
4K through HDMI and 8MP (3864x2228 pixels) capture resolution
Dedicated to documentation of microscopic results with a clear focus on maximum colour fidelity and fast live image
Does not require a computer for standard operation
Comes with an on-board software that will allow you to use it through its HDMI port, and with a mouse connected to the USB port of the camera
Package includes 12V Power Adapter, CS Ring, Motic 4-dot Calibration
Slide, HDMI Cable, Manual, 12mm lens, Adapter φ30/ φ38, Macro Tube


Moticam BMH4000X
Full HD standalone camera with LCD 11.6" monitor
C-Mount multitasking microscopy camera, that delivers an impressive 4K (3840*2160) Resolution Full HD live image with maximum colour fidelity on an integrated LCD screen
Does not require a computer for standard operation
Comes with an on-board software that will allow you use it through its 11 6" Full HD integrated screen, with a mouse connected to the USB port of the camera
Package includes 12V Power Adapter, CS Ring, Motic 4-dot Calibration Slide, HDMI Cable, Manual, 12mm lens, Adapter φ30/ φ38, Macro Tube
Pre-Packaged Microscope with BMH4000X Bundles
Comes with everything you need!
Each includes a microscope, a Moticam BMH4000X camera and a 0.35X c-mount adapter to complete the package.
Fisher Scientific Cat. No.
Trinocular Microscope
Advanced Biological Compound Microscope - BA310E
Basic Academical Lab Compound Microscope - Panthera E2
Perfect Lab Compound Microscope - Panthera C2
Routine Live Cell Inverted Microscope - AE2000
Flexible Advanced Stereo Microscope - SMZ-171-TLED
Moticam A Series
Digital cameras starter line
Flexibility through VARIATION, INHERIT knowledge to the next generation, SELECTING everything you need whilst saving TIME and being able to ADAPT
Ultimately developed and designed for newcomers in digital imaging and young explorers with ambitious goals
Simple to use, without time consuming training
Package includes CS ring adaptor, focusable lens, 30mm and 38mm eyepiece adapters, USB 2.0 cable, Motic 4-dot calibration slide, macro tube, Calibration card


Moticam X5
Streaming Wi-Fi camera
A compact Wi-Fi camera to share live images with up to 6 devices at the same time
Powerful high-res solution to turn your microscope into a Wi-Fi station
Use your computer with Motic Image Plus 3.1 Software for further image processing
Package includes CS ring adaptor, focusable lens, 30mm and 38mm eyepiece adapters, USB 2.0 cable, Motic 4 dot calibration slide, macro tube, Motic Images Plus 3.0 PC/OSX/Linux
Moticam BTI10
Wi-Fi microscopy solution with 10" tablet
Consisting of a 4MP camera with a built-in adjustable bracket that allows you to mount your own tablet
Camera can be connected via Wi-Fi to an iOS or Android tablet
Help microscope users visualize, edit and share the microscope images, enabling computer-free digital microscopy
Package includes CS ring adaptor, Motic 4-dot calibration slide, macro calibration card, universal power supply 100V-240V (CE)

PA43 BIO Series
Routine, clinical-lab grade microscopes
The PA43 BIO has a strong selection of contrast accessories that are available and easily upgradable to meet different requirements:
• Phase contrast methods for various microbiology applications.
• Darkfield accessories for blood cell studies for natural therapy.
• Polarizing contrast accessories for protein crystal, tissue, gout and kidney stone observations
Features
Kohler illumination with option of Halogen or LED illumination
Environmentally Friendly ECO function
Consistent, Even Illumination with IL Function
Rackless stage

Packages (Microscope + Camera)



PA53 BIO Series
Superior microscopy solutions, research grade
Ergonomic design helping to reduce user fatigue during extended periods of use
Feature intuitive control layout for optimized and efficient workflow
Equipped with transmitted, full Kohler 100W halogen illumination
Equipped with super wide-field FN23, diopter adjustable eyepieces
Come standard with multifunctional illumination control knobs
An automatic power saving mode is engaged whenever an operator leaves temporarily
Consistent and even Illumination with IL Function
Configuration) Fisher Scientific Cat. No. 01-257-419
Scientific Cat No 01-257-420


PA53 BIO FS6 Series
Multi-channel fluorescence for research
The coded fluorescence turret automatically remembers the fluorescence channel if changed
Close contact with the operating panel of the LUMOS light source ensures smooth handling and managing of multistained samples
Motic Fluorescence Imaging Software plug-in for Motic Images Plus 3.0 is included with all PA3 BIO FS6 packages. Expanded lifespan in comparison to mercury bulbs: Factor 100
Instant On/Off: Unlike traditional mercury-arc lamps which take up to 20 minutes to reach constant brightness, the LUMOS FL is ready for use at the flip of a switch
Individually control of each LED channel
PA53 MET Series
Ultimate metallurgical optical solutions
High-performance Motic objective lenses provide excellent clarity in any observation environment
Customizable optics and lighting systems
High-speed, high-efficiency, and intelligent functionality from our Latest Digital Technology
Creative imaging solutions with superior image processing capabilities
PA53MET-100W RI
Fisher Scientific Cat No 01-257-427
PA53MET-T-RTI
Fisher Scientific Cat. No. 01-257-429
PA53MET-BD-100W RI
Fisher Scientific Cat No 01-257-428

PA53MET-BD-T-RTI
Fisher Scientific Cat. No. 01-257-430
PA53MET-3D w/Software
Fisher Scientific Cat. No. 01-257-431
Panthera TEC MET Series

Instructional material science microscopes
High value for the inspection of semiconductors and compound materials
Brightfield, Darkfield and simple Polarization contrast are combined with a new segmental illumination
Compact Epi illuminator carries a slot for polarizer and analyzer, ready for Polarization contrast and to reduce internal reflections
The extended 22mm Field of View (FOV) offers 21% more visual area in comparison to a basic 20mm FOV system
The beam split of the trinocular versions (25° viewing angle) is fixed by 50/50 (vis/photo)
Incident/transmitted stand type for compound materials additionally carries a transmitted LED illumination system with 39 LEDs mounted in an LED condenser
MET (BF/RL 6x4 Stage) Fisher Scientific Cat No 01-674-201
(BF/RL/TL 6x4 Stage) Fisher Scientific Cat No 01-674-203
(BD/DF/RL 6x4 Stage)
Scientific Cat No 01-674-205
(BD/DF/RL/TL 6x4 Stage)
Scientific Cat No 01-674-207
Panthera TEC POL Series
Professional polarization microscopes
In incident light, a 3W LED is integrated in a Brightfield setup with Aperture and Field diaphragm
Feature UC Plan Achromat objectives with focus on mounting for maximum darkness of the image backgroun
A 5-fold encoded nosepiece memorizes the light inten objective position
The compact Epi illuminator carries a slot for polarizer a ready to set up Polarization contrast and to reduce intern
The incident/transmitted stands additionally carry a illumination with LED/Halogen interchangeability
The 360° rotatable stage runs smooth for an easy posit sample
Panthera TEC POL (BIN)
Fisher Scientific Cat No 01-674-208
Panthera TEC POL EPI (TRIN)
Fisher Scientific Cat No 01-674-211

Panthera TEC POL (TRIN
Fisher Scientific Cat No 01-674-209

Panthera TEC POL Digital
Fisher Scientific Cat No 01-674-212
Panthera TEC POL EPI Digital Fisher Scientific Cat. No. 01-674-213
SM7 CMO Stereo Zoom Series
Superior imaging quality
stereomicroscopes
Features an optical performance with true colour reproduction, high resolution and low distortion
Stand with Incident/Transmitted LED light supplies variable illumination
Ultra-flat stand bases for a relaxed positioning of hands and forearms facilitate lengthy preparation work
Advanced ergonomic design maximizes efficient usage and minimizes fatigue
Galilean Optics of the SM7 show a 7:1 Zoom system, resulting in a standard magnification range of 8X-56X
1X Plan-Apochromatic objective with a Working Distance of 81mm is available for the best possible image results
Resolution of the 1X Apochromatic objective which makes SM7 especially interesting for technical applications
A1X
Scientific Cat No 01-674-216
APO1X
Scientific Cat No 01-674-223
A1X
Scientific Cat No 01-674-217
APO1X Fisher Scientific Cat No 01-674-218 SM7-P A1X
Scientific Cat. No. 01-674-219
APO1X
Scientific Cat. No. 01-674-220
Scientific Cat. No. 01-674-221
Moticam S Series
Digital camera
Motic new sCMOS cameras, designed by German engineers and manufactured by professionals represent an impressive impetus to microscope camera performance. With a member of this product line the door for new application fields openswide. The accelerated data readout enables to work on fast phenomena in biology and industry

The Starting Point A Good Balance

Moticam S1
Fisher Scientific Cat. No. 01-257-464

Moticam S6
Fisher Scientific Cat. No. 01-257-466

Moticam ProS5 Lite
Fisher Scientific Cat. No. 01-257-470

Moticam S3
Fisher Scientific Cat No 01-257-465

Moticam S12
Fisher Scientific Cat. No. 01-257-468

Moticam ProS5 Plus
Fisher Scientific Cat. No. 01-257-471

Moticam S20
Fisher Scientific Cat. No. 01-257-469


Motic Instruments USA, Inc.
Member of the Motic Group

